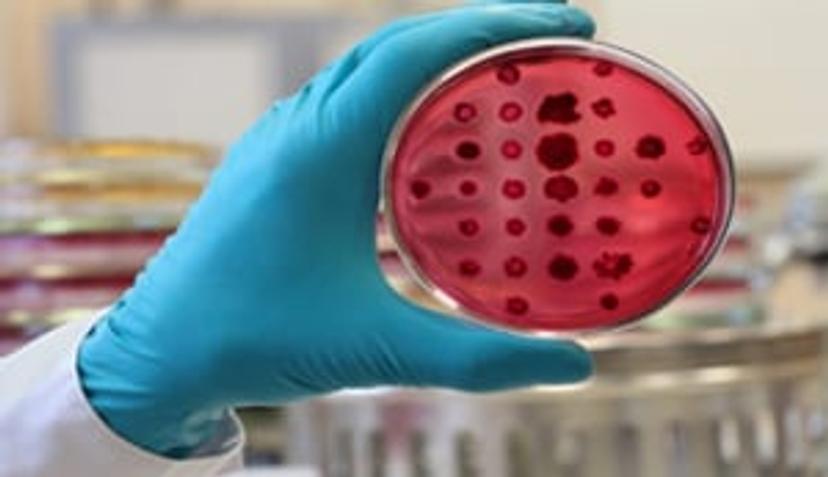

Latest Advances in Cell-Based Assays: Special Feature
From flow cytometry and kinetic analysis to porous membranes and liquid handling, find out the latest techniques and technologies advancing cell-based assays
3 May 2020


Flow cytometry: Dealing with the demands of modern drug discovery
Find out how advanced flow cytometry is meeting the demands of today's drug discovery pipelines by facilitating rapid analysis of complex cell-based models, in this white paper from Sartorius.

Vacuum filtration: Perform multiple filtrations simultaneously and save time
Discover how you can save time in your lab with the new vacuum filtration system from Sartorius, designed to cater for 50 mL volumes and speed up the cell line development process like never before.

Porous membranes: How can you simplify and enhance your cell analysis?
Learn how Millicell® inserts from Merck foster in vivo-like cell growth conditions to better support your research goals and discover the advantages of using microporous membranes in the labs.

Kinetic assays: Upgrade your ligand bias detection method using dual-channel assays
Discover the latest approaches used for effective kinetic analysis and find out how the CLARIOstar from BMG LABTECH can help you reliably detect agonist bias with more simplicity than ever.

Cell incubation: A new solution to your liquid handling process
Enhance your incubation processes by taking a look at the new solution for automated incubation. Learn how the compact INHECO SCILA platform instrument can reliably control temperature, atmosphere and CO2.
Cell culture: Is contamination compromising your data?
Find out how the Cytomat 10 automated incubator with a fully automated thermal decontamination system can advance your lab and help you achieve optimum cell culture and high-capacity cell growth.
Video interview with leading scientists:
Discover interviews with leading scientists in cell-based assay research below:
- How X-ray microscopy can be used to visualize viral mechanisms in living cells: Maria Harkiolaki at Diamond Light Source discusses how X-ray microscopy can effectively track viral replication and infection, and explores her role in designing user-friendly microscopes Watch the interview >>
- Discover how new biomicrofluidic devices can be used for intracellular delivery: In this video, Dr. Aram Chung at Korea University discusses his groundbreaking work fabricating microscale fluid flow devices for biomedical intracellular delivery, offering substantial benefits and new solutions to both biologists and physicians. Watch the interview >>
- Are you getting the most out of your image-based data? Dr. Anne Carpenter, Institute Scientist and Imaging Platform Senior Director, Broad Institute of MIT and Harvard, explains how her work aims to bridge the gap between biology and computational sciences by providing the software and strategies to get the most out of image-based data.Watch the interview>>
- Upgrade your ELISA by reducing testing turnaround times with the high-capacity EUROLabWorkstation: In this video, Justin Waldron, marketing manager for EUROIMMUN US, describes the new EUROLabWorkstation ELISA, a high-throughput, high-capacity ELISA processor that promises efficient sample loading and fast turnaround times. Watch the interview>>
Downloadable resources:
From cell culture workflows to cellular imaging, download the latest information here:
- Ultimate Cell Culture Workflow Compendium: This application compendium pulls together everything you need to ensure successful cell culture in your lab, including a range of compatible products and guides on how to use them most effectively. Download method>>
- Services for expression, purification, and scale production of proteins and immunoassays: In this application note, The Native Antigen Company provides insight into its key contracts and custom services, including construct design and cloning, protein expression, protein purification, antibody generation, and assay development. Download method>>
- Cellular imaging insights: In this exclusive eBook, Molecular Devices provides an overview of the new tools that can be used to better understand complex imaging models. Download method>>
Your recommendations:
Don't just take our word for it, see what researchers around the world are saying about the products they use! Lauren Zavan from La Trobe University shared her opinion of the CLARIOstar® Plus Multi-mode Microplate Reader by BMG LABTECH:

For more of the latest cell-based assay news, straight to your inbox, become a member of SelectScience for free today>>





